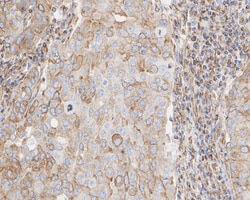
Invitrogen TUBB1 Recombinant Rabbit Monoclonal Antibody (JE01-23) 100 &mu;L;

missing translation for 'onlineSavingsMsg'
Learn More
Learn More
Invitrogen™ TUBB1 Recombinant Rabbit Monoclonal Antibody (JE01-23)


Rabbit Recombinant Monoclonal Antibody
Brand: Invitrogen™ MA556561
This item is not returnable.
View return policy
Description
TUBB1 Recombinant Monoclonal Antibody for Western Blot, ICC/IF, IHC (P), Flow
TUBB1 encodes a member of the beta tubulin protein family. Beta tubulins are one of two core protein families (alpha and beta tubulins) that heterodimerize and assemble to form microtubules. This protein is specifically expressed in platelets and megakaryocytes and may be involved in proplatelet production and platelet release. A mutations in this gene is associated with autosomal dominant macrothrombocytopenia. Two pseudogenes of this gene are found on chromosome Y.
Specifications
| TUBB1 | |
| Recombinant Monoclonal | |
| 1 mg/mL | |
| TBS with 0.05% BSA, 40% glycerol and 0.05% sodium azide; pH 7.4 | |
| A2AQ07, Q9H4B7 | |
| TUBB1 | |
| Synthetic peptide within human beta i tubulin aa 402-451/451. | |
| 100 μL | |
| Primary | |
| Human, Mouse, Rat, Monkey | |
| Antibody | |
| IgG |
| Flow Cytometry, Immunohistochemistry (Paraffin), Western Blot, Immunocytochemistry | |
| JE01-23 | |
| Unconjugated | |
| TUBB1 | |
| 2810484G07Rik; M(beta)1; tbb1; TUBB1; tubulin beta; tubulin beta 1 class VI; tubulin beta-1 chain; tubulin, beta 1 class VI | |
| Rabbit | |
| Protein A | |
| RUO | |
| 545486, 679312, 81027 | |
| Store at 4°C short term. For long term storage, store at -20°C, avoiding freeze/thaw cycles. | |
| Liquid |
Product Content Correction
Your input is important to us. Please complete this form to provide feedback related to the content on this product.
Product Title
Spot an opportunity for improvement?Share a Content Correction